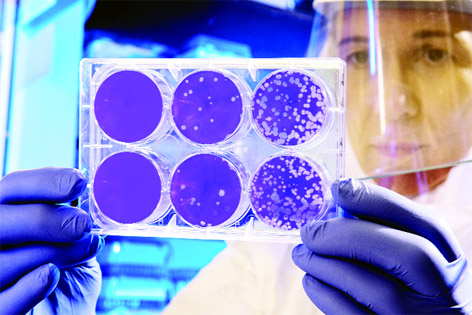

Dr.Vikas Roshan
The Nation is under threat because of corona virus and everyone is scared of it. Coronavirus disease (COVID-19) is an infectious disease caused by a newly discovered coronavirus(SARS-Cov-2).Most people infected with the COVID-19 virus will experience mild to moderate respiratory illness and recover without requiring special treatment. Older people, and those with underlying medical problems like cardiovascular disease, diabetes, chronic respiratory disease, and cancer are more likely to develop serious illness.
The main route of transmission of COVID-19 is via respiratory droplets generated when an infected person coughs or sneezes. Any person who is in close contact with someone who has respiratory symptoms (e.g., sneezing, coughing, etc.) is at risk of being exposed to potentially infective respiratory droplets. Droplets may also land on surfaces where the virus could remain viable for several hours to days and transmission through contact of hands with contaminated surfaces and person’s mucosa such as nose, mouth and eyes may occur.
If patient experience cough, shortness of breath, fever they should report to hospital/help desks.
At the time of crisis when the whole world is under the threat of highly infectious corona virus, I just want to make the small subset of population suffering from cancer and on some kind of anti-cancer treatment like surgery, radiotherapy and chemotherapy aware of certain facts. All above mentioned anticancer treatment decrease immunity and makes human body fertile for corona attack.
Oncology patients which are at risk are,
• Cancer patients who are undergoing active chemotherapy or radiotherapy.
• Cancer patients who are suffering from leukemia, lymphoma or myeloma who are at any stage of treatment
• People having immunotherapy or other continuing antibody treatments for cancer,
• Patients having other targeted cancer treatments which can affect the immune system, such as protein kinase inhibitors or PARP inhibitors.
• People who have had bone marrow or stem cell transplants in the last 6 months, or who are still taking immunosuppression drugs
There are certain measures that should be taken in this scenario
Avoid going to hospitals if there is no emergency and delay the follow ups. Consider the treatment breaks if risk of corona risk is high, the supportive fluids or injectables can be arranged at home after discussion with your physician.
There are certain questions that come to the mind during this emergency like situation when everything is under self-induced siege. I have tried to consult few published guidelines around the world regarding oncology care during this covid19 infection.
First question that comes to mind whether we should start the new patients on treatment or not. The answer as per guidelines is to categorize the oncology patients into risk groups according to the parameters like dividing rate of tumor cells(whether slow growing or fast growing tumours).rapidly proliferating tumours should be treated immediately without any delay. This is priority level one as discussed in literature.
Secondly the tumours that presented with spinal cord compression with some sort of physical deficit like weakness developing in arms and leg. Some tumours which causes superior venacaval obstruction that leads to breathlessness and facial edema. These are few indications that needs urgent palliative treatment.
Patients with active bleeding from any tumor site should need urgent care.
Thirdly few tumours which have good prognosis, like lesser proliferation rate, hormonal receptor positive patients, where chances of recurrence are less than 20% at 10 years( all these factors should be discussed in Tumor Board) treatment for these subsets can be delayed for few weeks at the discretion of oncologist.
Cancer patients with comorbidities like diabetes, hypertension ,on immunosuppressive drugs, patients who already underwent transplant( like liver transplant, kidney transplant etc. ) should take extreme cautions and maintain proper hygiene. Consult your physician for further management. The salient points that needs to be discussed about patients on radiotherapy.
• Patients who are on treatment should continue their treatment with necessary precautions.
• Personal protection for protection patients should use masks, frequent hand washes, frequent use of hand sanitizers.
• Oncology patients should avoid sitting or standing in crowd.
The care takers should also wear mask, avoid sneezing/coughing near patients.
(The author is Consultant Radiation Oncology American Oncology Institute, Jammu)
Trending Now
E-Paper